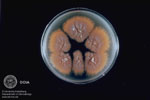
Microsporum furrugineum
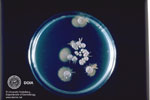
Candida albicans
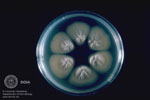
Trichosporon cutaneum

|
Wie wird die Diagnose gestellt?
a) klinische Untersuchung der Haut und Schleimhaut:
 Tinea corporis
|
Pilze können sehr unterschiedliche Hautveränderungen hervorrufen, die von kosmetischen Beeinträchtigungen bis zu schwerem Entzündungen reichen. Daher sollte die klinische Untersuchung durch einen Facharzt für Hautkrankheiten erfolgen. Typisch sind runde, randbetonte, teilweise schuppige Rötungen am Körper. An den Nägeln führen Pilze zu Verfärbungen und Verformungen. Am häufigsten sind gelbliche Verfärbungen, jedoch können sie je nach Erreger auch bräunlich-schwarz sein. Eine Pilzinfektion der behaarten Kopfhaut kann sich durch örtlichen Juckreiz, Schuppung, Brüchigkeit der Haare und später haarlose Bereiche mit abgebrochenen Haaren. Der Verlauf an der Kopfhaut ist häufig entzündlich mit Krusten und Eiterabsonderungen. An den Schleimhäuten (orogenital) machen sich Pilzinfektionen meist durch Juckreiz oder ein brennendes Gefühl bemerkbar. Klinisch sind weißliche Auflagerungen und Schleimhautrötungen sichtbar.
|
b) Nativpräparat (Blick unter dem Mikroskop)
 Pilzprotoplasten
|
Nach der klinischen Untersuchung wird durch den Hautarzt, meist während der Sprechstunde, ein Nativpräparat angelegt. Nach Desinfektion mit Isopropylalkohol wird das Material gewonnen, auf einen Objektträger aufgetragen und mikroskopisch beurteilt.
|
c) Pilzkultur (wächst auf speziellem Nährboden)
Microsporum furrugineum
|
Einen weiteren Bestandteil zur genauen Diagnose stellt die Pilzkultur dar. Nach der Gewinnung wird das Material auf ein Nährmedium aufgebracht und bei Raumtemperatur bis zu 4 Wochen lang aufbewahrt. Anschließend findet eine Beurteilung des makroskopischen Wachstumsbildes, der Farbstoffbildung und mikroskopisch der Ausbildung von Makro- und Mikrokonidien) statt. Es existieren verschiedene Nährböden, die häufig mit Substanzen zur Unterdrückung des Schimmelpilz- und Bakterienwachstums geiimpft sind. Falls kein Pilzwachstum erkennbar ist, wird die endgültige Beurteilung nach 4 Wochen durchgeführt
|
Candida albicans
|
|
|
Trichosporon cutaneum
|
|
|
d) Wood-Licht:
Einige Pilze bilden fluoreszierende Zwischenprodukte, die mit dem sog. Wood-Licht sichtbar gemacht werden können. Dabei wird das verdächtige Areal in einer dunklen Kammer beleuchtet und anhand der fluoreszierenden Farbe kann der Pilz festgestellt werden.
|